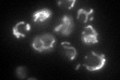
YMR062C

View description
Mitochondrial ornithine acetyltransferase, catalyzes the fifth step in arginine biosynthesis; also possesses acetylglutamate synthase activity, regenerates acetylglutamate while forming ornithine
Localization:
Intensity:
Fold change:
Significance:
-
C’ GFP library in SD
mitochondria95.38 -
N' NOP1pr-GFP in SD

N/A0 -
N' TEF2pr-mCherry in SD

N/A0 -
N' NATIVEpr-GFP in SD

N/A0 -
N' TEF2pr-VC and Cyto-VN in SD

N/A0 -
C’ GFP library in SD+DTT

mitochondria64.520.67No -
C’ GFP library in SD+H2O2

mitochondria95.961No -
C’ GFP library in Starvation Media

mitochondria46.150.48Yes -
C’ GFP library on the background of Pup2-DaMP

mitochondria -
C’ GFP library on the background of CCT mutant

mitochondria82.1830.86158No
